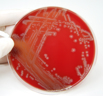
Agar Plate

Laboratories and Higher Risk Activities
The Biological Agents Regulations recognise that certain work activities have greater potential for exposure to biological agents. The Regulations set down special measures for healthcare and veterinary care facilities, laboratories, industrial processes and animal rooms. This area provides information on some of the control measures that would be used in such locations.